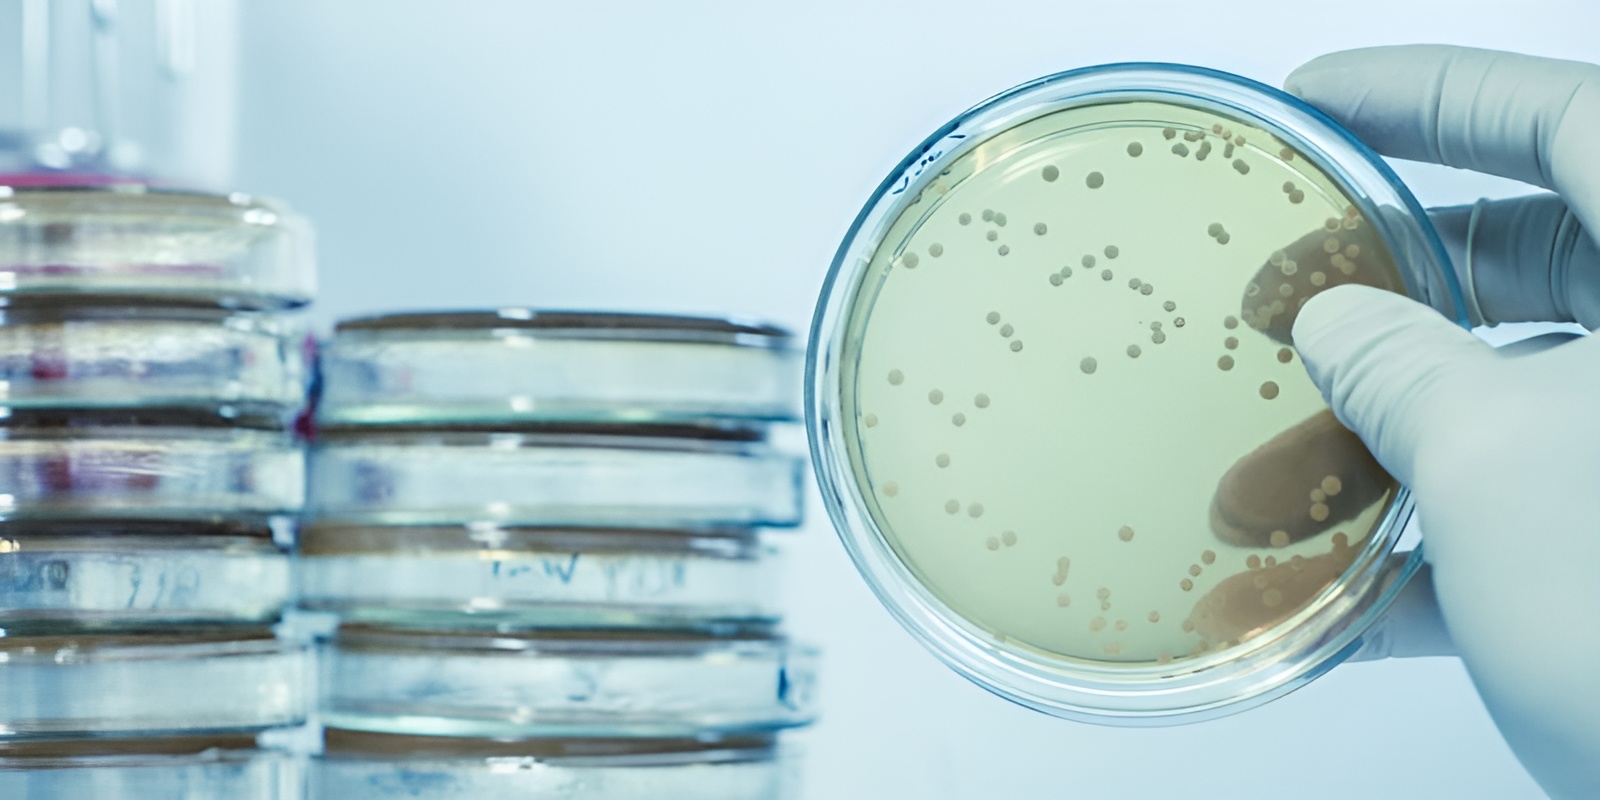
Ejemplo de Imagen informativa 3
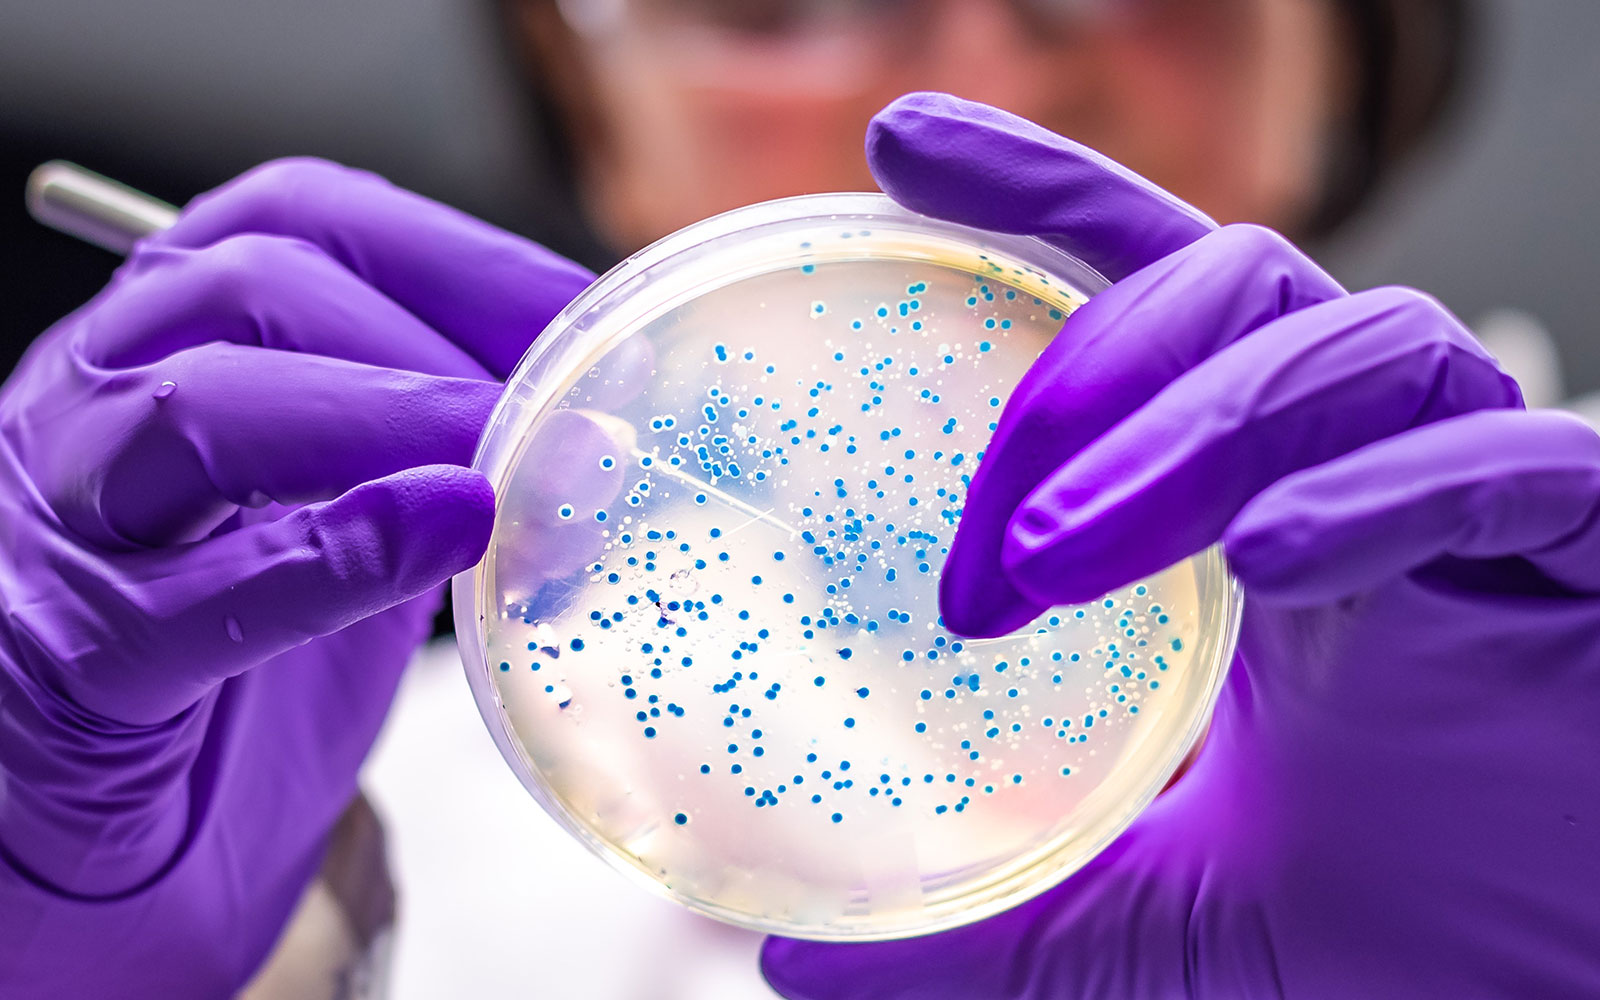
Ejemplo de Imagen informativa 4

Servicios
Química Clínica
Analizamos tu salud a fondo con estudios precisos y confiables. Desde glucosa hasta perfiles completos, te ayudamos a entender lo que tu cuerpo necesita. ¡Resultados rápidos y atención de calidad!

Hematología
Cuidamos tu salud desde la sangre. Detectamos anemia, infecciones y más con análisis detallados y confiables. ¡Resultados claros y un equipo listo para apoyarte!

Biología Molecular
Diagnósticos precisos desde el ADN. Detectamos virus, bacterias y alteraciones genéticas con tecnología avanzada y un trato humano, porque tu salud merece certeza y cuidado.

Microbiología
Identificamos bacterias, virus y hongos para ayudarte a prevenir y tratar infecciones a tiempo. Tecnología confiable, resultados precisos y un equipo que cuida de ti.
Parasitología
Detectamos parásitos que pueden afectar tu bienestar con estudios confiables y atención cercana. Porque tu salud intestinal también merece cuidado experto.
Inmunoquímica
Evaluamos hormonas, marcadores tumorales y más con tecnología de punta. Resultados precisos para un diagnóstico confiable y a tiempo.

Serología
Detectamos anticuerpos para conocer si has tenido contacto con virus, bacterias u otros agentes. Ideal para diagnósticos, controles y tranquilidad.

Urianálisis
Un vistazo completo a tu salud a través de la orina. Detectamos infecciones, problemas renales y más con resultados rápidos y confiables.

Perfiles PCR - TR COVID 19
Encontramos el virus de forma rápida y confiable. Ya sea con prueba PCR o test rápido (TR), te ayudamos a saber con certeza y a tiempo. ¡Cuida de ti y de los tuyos!

Pruebas de Detección de Cáncer
La prevención que salva vidas. Realizamos análisis especializados para detectar marcadores tumorales y ayudarte a tomar decisiones a tiempo. Tu salud, nuestra prioridad.
